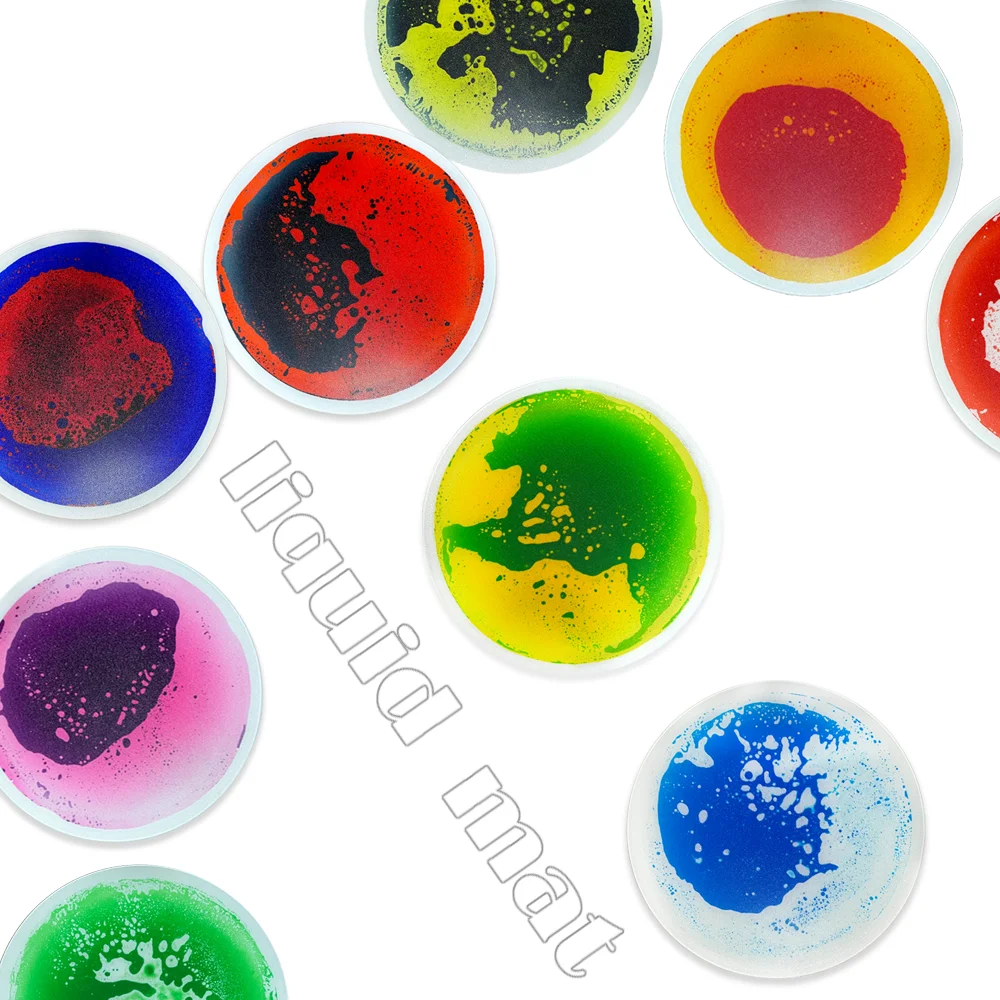
Autism Sensory Toy  Manufacturer Customized colorful Baby Non-toxic Liquid Play Mat Sensory Equipment Mats For Autistic Children

Autism Sensory Toy Manufacturer Customized colorful Baby Non toxic Liquid Play Mat Sensory Equipment Mats For Autistic Children
- Category: >>>
- Supplier: Dongguan Hengfu Plastic Products Co. Ltd.
Share on (1600570541518):
Product Overview
Description
Specification
item | value |
Type | Other Educational Toys |
Gender | Unisex |
Age Range | 2 to 4 Years, 5 to 7 years, 8 to 13 Years, 14 Years & up |
Place of Origin | China |
Guangdong | |
Brand Name | HF |
Model Number | HF045 |
Product Type | Other Educational Toys |
Material | PVC |
Surface Treatment | Scrub |
Product size | 50*50*0.6CM |
Feature | Eco Friendly |
Application | Hotel, School;dance room ,kid room,kindergarten;nursery |
Style | Eductional Kid Toys |
Weight | 13kg |
Product Name | 3d liquid tiles |
Package | 4pcs/6pcs/9pcs per carton |
Product Description
Details Images




Packing & Delivery




The product packaging box can be customized from 500pcs.6 directions is wrapped with pearl cotton, and each piece is separated by pearl cotton. 4 \\ 6 \\ 9psc in an outer box.(also negotiable)
Company Profile



EstablishedonNovember16,2020,DongguanHengfuplasticproductsCo.,Ltd.focusingonR&Dproductionofsensoryandeducationaltoys.Weareprofessionalmanufacturerandexporterthatisconcernedwiththedesign,developmentandproductionofliquidfloor,children'scolorfloor,children'spuzzlefloorandfloormat.Ourwell-equippedfacilitiesandexcellentqualitycontrolthroughoutallstagesofproductionenablesustoguaranteetotalcustomersatisfaction.Ourcompany'sproductshavepassedCA65,EN71-1,EN71-2,EN71-3testing,andappliedformanypatents.Sinceitsfoundation,thecompanykeepslivinguptothebeliefof:"honestselling,bestquality,Win-win!"Wepromisethatwe'llberesponsibleallthewaytotheendonceourservicesbegin.
Certifications

FAQ
1. who are we?
We are based in Guangdong, China, start from 2020,sell to North America(40.00%),Southeast Asia(20.00%),Eastern Europe(20.00%),Domestic Market(10.00%),South Asia(10.00%). There are total about 11-50 people in our office.
2. how can we guarantee quality?
Always a pre-production sample before mass production;
Always final Inspection before shipment;
3.what can you buy from us?
liquid floor mat,liquid floor tile,Sensory toy
4. why should you buy from us not from other suppliers?
EstablishedonNovember16,2020,DongguanHengfuplasticproductsCo.,Ltd.focusingonR&Dproductionofsensoryandeducationaltoys.Weareprofessionalmanufacturerandexporterthatisconcernedwiththedesign,developmentandproductionofliquidfloor,children'scolorfloor,children'sp
5. what services can we provide?
Accepted Delivery Terms: FOB,CFR,CIF,EXW,DDP;
Accepted Payment Currency:USD,EUR,JPY,CAD,AUD,HKD,GBP,CNY,CHF;
Accepted Payment Type: T/T,L/C,D/P D/A,MoneyGram,Credit Card,PayPal,Western Union,Cash,Escrow;
Language Spoken:English,Chinese,Spanish,Japanese,German,French,Russian,Korean,Italian
We are based in Guangdong, China, start from 2020,sell to North America(40.00%),Southeast Asia(20.00%),Eastern Europe(20.00%),Domestic Market(10.00%),South Asia(10.00%). There are total about 11-50 people in our office.
2. how can we guarantee quality?
Always a pre-production sample before mass production;
Always final Inspection before shipment;
3.what can you buy from us?
liquid floor mat,liquid floor tile,Sensory toy
4. why should you buy from us not from other suppliers?
EstablishedonNovember16,2020,DongguanHengfuplasticproductsCo.,Ltd.focusingonR&Dproductionofsensoryandeducationaltoys.Weareprofessionalmanufacturerandexporterthatisconcernedwiththedesign,developmentandproductionofliquidfloor,children'scolorfloor,children'sp
5. what services can we provide?
Accepted Delivery Terms: FOB,CFR,CIF,EXW,DDP;
Accepted Payment Currency:USD,EUR,JPY,CAD,AUD,HKD,GBP,CNY,CHF;
Accepted Payment Type: T/T,L/C,D/P D/A,MoneyGram,Credit Card,PayPal,Western Union,Cash,Escrow;
Language Spoken:English,Chinese,Spanish,Japanese,German,French,Russian,Korean,Italian
We Recommend
New Arrivals
New products from manufacturers at wholesale prices